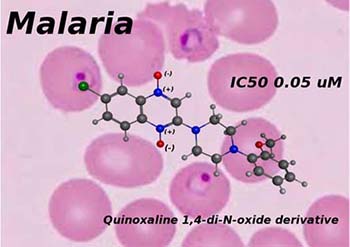

vol. 5, No. 6, 2013, p. 1051-1209
Procedimentos de Submissão para Open Access
Os manuscritos submetidos na Revista Virtual de Química (RVq) adotam a implementação total do sistema open access, onde os autores contribuem com parte dos custos da Publicação de seus artigos. Ver mais...
Oportunidades e Desafios para a Inovaçao em Fármacos: Agora ou Nunca!
Eliezer J. Barreiro, Angelo C. Pinto

http://dx.doi.org/10.5935/1984-6835.20130078
Reaçao de Beirut e sua Aplicaçao na Síntese de Compostos Quinoxalina-N,N'-Dióxidos Bioativos
Lídia M. Lima, Daniel N. do Amaral

http://dx.doi.org/10.5935/1984-6835.20130079
Derivados 1,4-di-N-óxido Quinoxalinas: O Interesse no Tratamento da Doença de Chagas
Elsa Moreno-Viguri, Silvia Pérez-Silanes

http://dx.doi.org/10.5935/1984-6835.20130080
Biotransformaçao Anaeróbia de Heterociclos Aromáticos Contendo N-óxido por Líquido Ruminal de Bovinos
Victoria Cerecetto, Florencia Diaz-Viraqué, Ignacio Irazoqui, Alfonso Rodríguez, Cecilia Cajarville, José Luis Repetto, María Laura Lavaggi, Mercedes González, Hugo Eduardo Cerecetto

http://dx.doi.org/10.5935/1984-6835.20130082
N- e O-Reaçao de 5,10-Dióxido de 2-Amino e 2-Hidroxifenazina Via Irradiaçao de Micro-ondas
Maria Laura Lavaggi, Mariana Gonda, Hugo Cerecetto, Mercedes González

http://dx.doi.org/10.5935/1984-6835.20130083
Antagonistas MCH-R1 como Potenciais Fármacos Anti-obesidade. Estratégias de Design e Relaçao Estrutura-atividade
Gildardo Rivera, Antonio Moreno, Virgilio Bocanegra-García

http://dx.doi.org/10.5935/1984-6835.20130084
Compreendendo as Formas Sólidas de 5E-(feniletenil)benzofuroxano com Diferente Atividade anti-T. cruzi in vivo
Sara B. Honorato, Williams Porcal, Alicia Merlino, Javier Ellena, Hugo Cerecetto, Alejandro P. Ayala, Mercedes González

http://dx.doi.org/10.5935/1984-6835.20130085
Depoimentos de Ex-alunos e Colaboradores
Silvia P. Silanes, Ignacio A. Moraza, Silvia G. Ruiz, José I. RecaldeIrurzun, Ana Maria Ochoa R. Mendibil, Victor Martínez-Merino, Yolanda S. Sánchez, Juan Carlos del Castillo, Estrella G. Alvarez, Patricio H. Gómez, Teresa Alvarez, Gildardo R. Sánchez, Argimiro Rivero, Luis Orts, Estefanía Berjón, Lidia M. Lima, Mercedes González, Hugo Cerecetto

http://dx.doi.org/10.5935/1984-6835.20130086
Cloreto de Tionila (CAS No 7719-09-7)
Daniel N. Do Amaral

http://dx.doi.org/10.5935/1984-6835.20130087
Editoria da RVq - Editoria da RVq - PubliSBQ
Instituto de Química, Universidade Federal Fluminense,
Campus do Valonguinho, 24020-141, Centro, Niterói-RJ, Brasil
E-mail: rvq@sbq.org.br